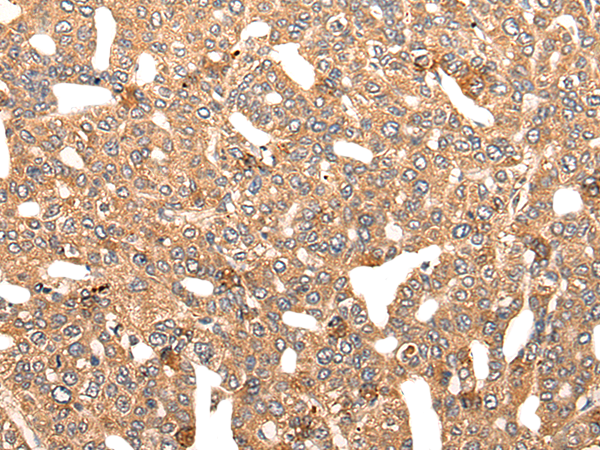
一抗

中文名稱 : 兔抗NOL8多克隆抗體
英文名稱 : Anti-NOL8 rabbit polyclonal antibody
別 名 : NOP132; C9orf34; bA62C3.3; bA62C3.4
儲 存 : 冷凍(-20℃)
抗 原 : NOL8
宿 主 : Rabbit
反應種屬 : Human
相關類別 : 一抗
標 記 物 : Unconjugate
克隆類型 : rabbit polyclonal
技術規格
|
Background: |
NOL8 binds Ras-related GTP-binding proteins (see MIM 608267) and plays a role in cell growth (Sekiguchi et al., 2004 [PubMed 14660641]). Plays an essential role in the survival of diffuse-type gastric cancer cells. Acts as a nucleolar anchoring protein for DDX47. May be involved in regulation of gene expression at the post-transcriptional level or in ribosome biogenesis in cancer cells. |
|
Applications: |
ELISA, IHC |
|
Name of antibody: |
NOL8 |
|
Immunogen: |
Synthetic peptide of human NOL8 |
|
Full name: |
nucleolar protein 8 |
|
Synonyms: |
NOP132; C9orf34; bA62C3.3; bA62C3.4 |
|
SwissProt: |
Q76FK4 |
|
ELISA Recommended dilution: |
5000-10000 |
|
IHC positive control: |
Human colorectal cancer and human lung cancer |
|
IHC Recommend dilution: |
20-100 |


 購物車
購物車 幫助
幫助
 021-54845833/15800441009
021-54845833/15800441009